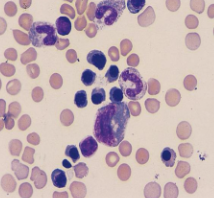
term image

Body Fluids Cells Exam 1
0.0(0)
0.0(0)
Card Sorting
1/25
There's no tags or description
Looks like no tags are added yet.
Study Analytics
Name | Mastery | Learn | Test | Matching | Spaced |
|---|
No study sessions yet.
26 Terms
1
New cards

top: hematoidin bilirubin
Bottom: erythropagocytosis
2
New cards
3
New cards

ependymal cell
4
New cards

choroid plexus
5
New cards

C. neoformans
6
New cards

amoeba (N. fowleri)
7
New cards

PMNs
8
New cards

lymphs
9
New cards
10
New cards

monos/macrophages
11
New cards

erythrophage
12
New cards

erythrophage with hemosiderin
13
New cards

bacteria in PMNs-N. meningiditis
14
New cards

bacteria in PMNs-S. pneumo or S. agalactiae (clusters)
15
New cards

monos and lymphs
16
New cards
nRBCs-possible traumatic tap
17
New cards

eosinophils-Brain parasite or medical device
18
New cards

macrophages
19
New cards

choroid plexus
20
New cards

spindle fiber cells
21
New cards

mestasis (blasts)
22
New cards

blasts
23
New cards

blasts
24
New cards

BM contamination
25
New cards

cryptococcus
26
New cards

fecal fat stained with Sudan Black III